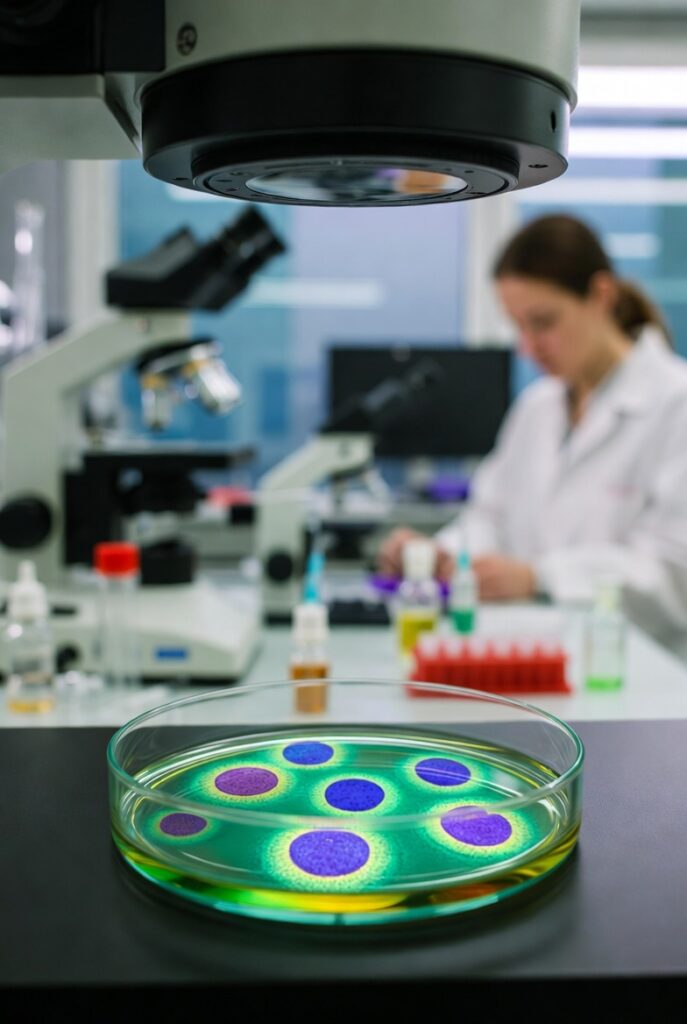

Controlled Effects in Regenerative Medicine
Localized, Non-Psychoactive Serotonergic Innovations Reversing Cellular Decline Inspired by Landmark Research (PMID 40628762)

Tryptamine-Based Regenerative Therapies
Our Platform
We are developing a portfolio of localized delivery systems using psilocin- functional analogs. All formulations are designed to be non-psychoactive and focus on specific tissues:
- Nasal compositions for olfactory regeneration
- Inhaled formulations for pulmonary tissue support
- Topical preparations for skin, hair and genital rejuvenation
- Ophthalmic and otic drops for sensory restoration
- Injectable solutions for systemic organ rejuvenation
- Self-limiting oral and ambient formats for wellness applications
Patents pending.

Innovative Delivery Systems
Cutting-edge formulations targeting skin, sensory, and organ rejuvenation with precision control.

Localized Controlled Effects
Proprietary methods ensure targeted, safe, and effective therapeutic outcomes without systemic impact.

Serotonergic Geroprotection Science
Leveraging serotonergic pathways to develop groundbreaking regenerative treatments based on solid research.

Diverse Application Formats
Advanced nasal, topical, inhaled, and injectable options crafted for versatile therapeutic use.

